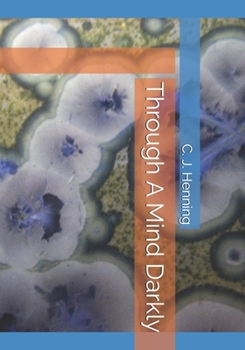
Paperback Through A Mind Darkly Book

Through A Mind Darkly
No Synopsis Available.
Format:Paperback
Language:English
ISBN:1690164522
ISBN13:9781690164524
Release Date:September 2019
Publisher:Independently Published
Length:102 Pages
Weight:0.42 lbs.
Dimensions:0.2" x 7.0" x 10.0"
Customer Reviews
0 rating